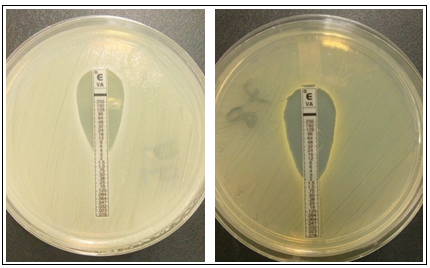

Staphylococcus spp. resistentes em hemoculturas e superfícies hospitalares e a segurança do paciente
Staphylococcus spp. resistant in blood cultures and hospital surfaces and the patient safety
Staphylococcus spp. resistentes en hemocultivos y superficies hospitalarias y la seguridad del paciente
Staphylococcus spp. resistentes em hemoculturas e superfícies hospitalares e a segurança do paciente
Revista de Epidemiologia e Controle de Infecção, vol. 7, núm. 4, pp. 260-266, 2017
Universidade de Santa Cruz do Sul

Recepción: 25 Noviembre 2016
Aprobación: 09 Agosto 2017
Resumo: Justificativa e Objetivos: Este estudo teve como objetivo avaliar a presença e resistência de Staphylococcus aureus e estafilococos coagulase-negativos resistentes à oxacilina isolados em superfícies e hemoculturas em uma Unidade de Terapia Intensiva de um hospital de emergência na cidade de Caruaru, Pernambuco, Brasil. Métodos: Trata-se de um estudo descritivo, do tipo transversal, sendo as coletas realizadas a partir das superfícies dos leitos de uma Unidade de Terapia Intensiva (UTI). Paralelamente, amostras de hemoculturas dos respectivos pacientes também foram obtidas. As amostras foram coletadas por amostragem de conveniência e a identificação dos microrganismos isolados se deu através de espectrometria de massas. Resultados: Observou-se uma prevalência maior de bactérias do grupo dos Staphylococcus coagulase negativo-SCN (76,92%) em relação à espécie de Staphylococcus aureus (23,07%). Dentre os microrganismos identificados como resistentes à oxacilina, 12,5% das espécies apresentaram semelhança nas amostras de superfície do leito e hemocultura do mesmo paciente. Conclusões: As bactérias resistentes identificadas reforçam a importância de enfatizar as medidas gerais de higienização do ambiente no que se refere a segurança do paciente nos serviços de saúde.
Palavras-chave: Infecção Hospitalar, Contaminação de Equipamentos, Unidades de Terapia Intensiva, Infecções Estafilocócicas.
Abstract: Justification and Objectives: This study aimed to evaluate the presence and resistance of Staphylococcus aureus and coagulase-negative Staphylococci resistant to oxacillin isolated in surfaces and blood cultures in an Intensive Care Unit of an emergency hospital in the city of Caruaru, Pernambuco, Brazil. Methods: This is a descriptive, cross-sectional study, the collections being performed from the bed surfaces of an Intensive Care Unit (ICU). In parallel, blood samples from the respective patients were also obtained. Samples were collected by convenience sampling and the identification of the isolated microorganisms was done by mass spectrometry. Results: We observed a higher prevalence of bacteria from the group of coagulase-negative Staphylococci - CoNS (76.92%) in relation to the species Staphylococcus aureus (23.07%). Among the microorganisms identified as resistant to oxacillin, 12.5% of the species were similar in the bed surface samples and blood cultures from the same patient sample. Conclusions: Resistant bacteria identified reinforce the importance of emphasizing the general measures of environmental hygiene in relation to patient safety in health care.
Keywords: Cross Infection, Equipment Contamination, Intensive Care Units, Staphylococcal Infections.
Resumen: Justificación y Objetivos: Este estudio tuvo como objetivo evaluar la presencia y resistencia de Staphylococcus aureus y estafilococos coagulasa-negativos resistentes a la oxacilina aislados en superficies y hemocultivos en una Unidad de Terapia Intensiva de un hospital de emergencia en la ciudad de Caruaru, Pernambuco, Brasil. Métodos: Se trata de un estudio descriptivo, del tipo transversal, siendo las colectas realizadas a partir de las superficies de los lechos de una Unidad de Terapia Intensiva (UTI). Paralelamente, se obtuvieron muestras de hemocultivos de los respectivos pacientes.Entre los microorganismos identificados como resistentes a la oxacilina, el 12,5% de las especies presentaron semejanza en las muestras de superficie del lecho y hemocultura del mismo paciente. Conclusiones: Las bacterias resistentes identificadas refuerzan la importancia de enfatizar las medidas generales de higienización del ambiente en lo que se refiere a la seguridad del paciente en los servicios de salud.
Palabras clave: Infección Hospitalaria, Contaminación de Equipos, Unidades de Cuidados Intensivos, Infecciones Estafilocócicas.
INTRODUCTION
The Intensive Care Units (ICUs) are considered a critical hospital environment due, among other factors, the significant occurrence of infections by multidrug-resistant bacteria. These infections make the alternative treatment being reduced, extending the period of hospitalization of patients, raising costs for the hospital and generating increased mortality rates. The knowledge of the microbiota of each ICU is important in order to contribute in a more targeted and rational use of antibiotics.1,2
Colonized and infected patients may contaminate the environment, turning inanimate surfaces and equipment potential reservoirs of bacteria, particularly the resistant to antimicrobials3. The importance of the environment as a reservoir of microorganisms was approached, especially in recent decades, when it was considered a secondary factor in the transmission of nosocomial infections, which are those acquired in the hospital during the delivery of health care or a few days after discharge from patient including bloodstream infections.4,5
The realization of blood cultures represents a significant role in the diagnosis of infections, in order to verify the occurrence of the microorganisms that cause bacteremia6. The frequency of pathogenic Gram positive isolated organisms, especially Staphylococcus aureus and coagulase-negative Staphylococci (CoNS), have increased significantly in ICU environments.2,7,8 The nasal cavity has been identified as the most prevalent region for the isolation of these microorganisms in hospitalsowever, the hands have also been considered an important mean of bacterial transmission in the hospital between patients and professionals, contributing to the increase of cross-infection cases9.
The frequent use of penicillins, such as methicillin and oxacillin in the treatment of staphylococcal infections, favored the emergence of strains resistant to these antibiotics, called ORSA/ORCS, these microorganisms generally exhibit extended resistance to all β-lactam antibiotics and were first recognized as nosocomial pathogens.10These strains are considered ORSA due to the production of penicillinase enzyme that confers resistance to semi-synthetic penicillins (methicillin/oxacillin) and β-lactam antibiotics making difficult the treatment of staphylococcal infections.11 The resistance to oxacillin presented by Staphylococcus is determined by the presence of a mecA gene located on chromosome.12
The recurring increased rates of ORSA strains, brings great interest on the bodies responsible for the control of nosocomial infections.13 The tracking of these microorganisms by appropriate methods, should be extended not only to laboratory testing of patients, particularly blood cultures, but also to the environment which the patients rests, like inanimate surfaces near then, given that different resistant organisms have been reported as possible causes of cross-infection.13-15
Nosocomial infections can be controlled through effective measures that interfere with the microorganism transmission process, such as frequent hand washing, proper cleaning of equipment and surfaces of beds, the use of personal protective equipment and the adoption of aseptic measures.15
This study aimed to evaluate the presence and resistance profile of Staphylococcus aureus and coagulase-negative Staphylococci resistant to oxacillin isolated in surfaces and blood cultures in an Intensive Care Unit of an emergency hospital in the city of Caruaru, Pernambuco, Brazil.
METHODS
Cross-sectional study, conducted between April 2015 and April 2016, on the ICU of a hospital emergency in the city of Caruaru, Pernambuco, Brazil. The study hospital has 225 beds for hospitalization, 19 of these composing the adult ICU. The unit belongs to the macro-regional health population of Caruaru, which covers 87 municipalities of the micro-regions of Caruaru, Garanhuns, Arcoverde, Afogados da Ingazeira and Serra Talhada, being a reference in traumatology, traumato-orthopedics, surgery general and maxillofacial complex of high complexity.
The blood bottles were supplied by the hospital to the study participants on spontaneous demand, according to the diagnostic routine performed by the Laboratory of Clinical Microbiology by BD BACTEC ™ Instrumented Blood Culture Systems (Becton, Dickinson and Company), previously collected as their own methodology of aseptic standards, with inclusion criteria patients admitted to the ICU hospital for a maximum of two months during the study period. The biological samples obtained from blood culture were seeding in Blood Agar, MacConkey Agar and Mueller Hinton bacterial isolation purposes and implementation of standardized test of antimicrobial susceptibility.
The collections of inanimate surfaces were performed by convenience sampling from five pre-defined surfaces of the ICU bed (right and left bars of the beds, bed control buttons, bedside table and buttons from the infusion pump). The inclusion criterion was samples from surfaces whose beds were occupied by their respective patients with positive blood culture indication by BD BACTEC™ Instrumented Blood Culture Systems. The obtainment of samples was performed by using moistened sterile swabs on Tryptic Soy Broth (TSB), that immediately after the collection were stored in tubes containing the broth and incubated in a greenhouse at a temperature of 37ºC for 24 hours for analysis of the bacterial growth. After checking the turbidity in TSB was performed by seeding exhausted in blood agar and MacConkey, incubated in 37ºC for 24 hours.
The genus level identification and species of isolated microorganisms was made by mass spectrometry type MALDI-TOF (Matrix Associated Laser Desorption-Ionization - Time of Flight). The mass spectra were obtained in duplicate and compared with the stored software database Biotyper MALDI 2.0 (Bruker Daltonics) for the identification of bacterial genus and species.
The identified bacteria were subjected to the antibiogram carried by the diffusion method of Kirby-Bauer and for analyzing of the results regarding the resistance patterns, it was used the standardize of the Clinical and Laboratory Standards Institute 2016 (CLSI).16 Discs containing the following antimicrobials were used: ciprofloxacin, nitrofurantoin, trimethoprim/sulfamethoxazole, chloramphenicol, cefoxitin, tetracycline, amikacin, erythromycin, clindamycin and gentamicin. The tracking of ORSA and ORCNS occurred by the use of cefoxitin antimicrobial, which is a surrogate marker for detection of oxacillin resistance in strains that have the gene mecA8. For the isolates classified as ORSA/ORCNS by disk diffusion method (Kirby-Bauer method), a test was performed to determine the minimum inhibitory concentration (MIC) for the antibiotic vancomycin using strips containing different concentrations of this antimicrobial agent (E-test®). This method was used to determine with certainty the phenotypic resistance pattern ORSA strains and ORCNS front vancomycin.
This work was approved by the Research Ethics Committee of the Centro Universitário Tabosa de Almeida (ASCES-UNITA) through the number 1.061.201.
RESULTS
Samples from 12 ICU beds were obtained and a sample of blood culture of the corresponding patient bed, totaling 60 samples of environmental surfaces and 12 blood cultures.
The bacterial growth was detected in 52 (86.66%) surfaces samples, 4 of them (7.69%) positive for the growth of more than one microorganism, totaling 57 bacteria species identified (Table 1).
| BED | LEFT BAROF THE BED | RIGHT BAR OF THE BED | BED CONTROLS OF THE BED | SHELF SUPPORT | INFUSION PUMP BUTTONS |
| B1 | Staphylococcus epidermidis e Bacillus cereus | Staphylococcus hominis e Bacillus cereus | Enterococcus faecalis | Staphylococcus epidermidis | Enterococcus faecalis |
| B2 | Acinetobacter baumannii | Acinetobacter baumannii | Bacillus cereus | Staphylococcus epidermidis | Staphylococcus epidermidis |
| B3 | Acinetobacter baumannii | Acinetobacter baumannii | Staphylococcus haemolyticus | N/G | Staphylococcus cohnii e Bacillus cereus |
| B4 | Acinetobacter baumannii | Escherichia coli | Staphylococcus aureus | Staphylococcus aureus eEnterococcus faecalis | N/G |
| B5 | Bacillus cereus e Staphylococcus warneri | Bacillus cereus | Acinetobacter baumannii | Acinetobacter baumannii | Bacillus weihenstephanensis |
| B6 | Staphylococcus haemolyticus | Bacillus flexus | Staphylococcus aureus | Staphylococcus haemolyticus | Providencia stuartii |
| B7 | Providencia stuartii | Acinetobacter baumannii | Acinetobacter baumannii | N/G | N/G |
| B8 | Pseudomonas aeruginosa | Pseudomonas aeruginosa | Proteus mirabilis | Acinetobacter baumannii | Proteus mirabilis |
| B9 | Klebsiella pneumoniae | Klebsiella pneumoniae | Bacillus cereus | Acinetobacter baumannii | Bacillus cereus |
| B10 | Acinetobacter baumannii | N/G | N/G | Enterococcus faecalis | N/G |
| B11 | Acinetobacter baumannii | Klebsiella pneumoniae | Acinetobacter pittii | N/G | Acinetobacter baumannii |
| B12 | Enterococcus faecalis | Klebsiella pneumoniae | Klebsiella pneumoniae | Providencia stuartii | Enterococcus faecalis |
Regarding isolated environmental species, there was a prevalence of Staphylococcus epidermidis representing 30.76% of total isolated, followed by S. aureus (23.07%) and S. haemolyticus (23.07%) and S. cohnii (7.69%), S. hominis (7.69%) and S. warnerii (7.69%) (Figure 1). As surfaces where these species were isolated, they are described in table 1.

Other organisms found included Acinetobacter baumannii, Acinetobacter pitii, Bacillus cereus, Bacillua flexus, Bacillus weihenstephanensis. Enterococcus faecalis, Klebsiella pneumoniae, Providencia stuartii, Proteus mirabilis, Pseudomonas aeruginosa and Escherichia coli, (Table 1).
Among the 12 analyzed blood cultures, a total of 10 (83.33%) samples showed growth on agar plates, and S. epidermidis (40% of total isolated), S. haemolyticus (20%), S. hominis and S. caprae (10% isolates each), gram positive isolates key (Graphic 2). Klebsiella pneumoniae presented in 2 (20%) of the analyzed blood cultures (Figure 2).

The antibiograms analyzed showed profile resistance of 21 strains Gram positive, the group of Staphylococci, 13 (61.9%) isolated on surfaces of samples, and 8 (38.09%) of blood cultures. Of these, 16 (76.19%) were resistant to cefoxitin (surrogate marker for detection of oxacillin resistance), are classified as ORSA/ORCNS, respectively (Table 2).
| MICROORGANISM | BED | SAMPLE SOURCE | *FOX | NIT | SXT | CLO | CIP | TE | CN | AMI | E | DA | MIC (mcg/mL) |
| Staphylococcus hominis | 01 | BLOOD CULTURE | R | S | R | S | S | R | S | S | R | R | 2 |
| Staphylococcus epidermidis | 01 | SURFACE | R | S | R | I | S | S | R | R | R | R | 4 |
| Staphylococcus hominis | 01 | SURFACE | R | S | R | S | S | S | S | S | R | R | 2 |
| Staphylococcus epidermidis | 01 | SURFACE | R | S | R | R | R | R | S | S | R | R | 3 |
| Staphylococcus haemolyticus | 02 | BLOOD CULTURE | R | S | R | R | S | S | R | S | R | R | 2 |
| Staphylococcus epidermidis | 02 | SURFACE | R | S | R | S | S | S | R | S | R | R | 2 |
| Staphylococcus haemolyticus | 03 | BLOOD CULTURE | R | S | R | R | R | S | R | S | R | R | 3 |
| Staphylococcus haemolyticus | 03 | SURFACE | R | S | R | R | R | S | R | S | R | R | 2 |
| Staphylococcus aureus | 04 | SURFACE | R | S | S | S | R | S | S | S | R | R | 2 |
| Staphylococcus epidermidis | 05 | BLOOD CULTURE | R | R | R | S | R | S | R | S | R | R | 4 |
| Staphylococcus epidermidis | 06 | BLOOD CULTURE | R | S | S | R | R | S | S | S | R | R | 3 |
| Staphylococcus aureus | 06 | SURFACE | R | S | S | S | R | S | S | S | R | R | 2 |
| Staphylococcus haemolyticus | 06 | SURFACE | R | S | R | S | I | R | R | S | R | R | 4 |
| Staphylococcus haemolyticus | 06 | SURFACE | R | S | R | S | I | S | S | S | R | R | 2 |
| Staphylococcus epidermidis | 08 | SURFACE | R | S | R | R | S | S | R | S | R | R | 2 |
| Staphylococcus epidermidis | 10 | SURFACE | R | I | S | S | S | R | S | S | R | R | 2 |
Regarding MIC determination, all strains tested had MIC ≤ 2 μg / mL for Staphylococcus aureus and ≤ 4 μg / mL Staphylococcus cuagulase negative (Table 2), thus being considered sensitive to vancomycin according to CLSI 2016, as shown in Figure 1, which presents halos with diameters that remit sensitivity to the tested antibiotic16
DISCUSSION
Frequent nosocomial infection outbreaks cases are related to environmental contamination. Cross infection can be facilitated by the survival of microorganisms on dry surfaces, and the Staphylococciare one of the most important microorganisms associated with Health Care Related Infections (HCRI), especially in Intensive Care Units (ICU).15,17
Contamination lying around the ICU patients was observed in the present study in 95% of the collected samples. For positive Gram, we observed a higher prevalence of bacteria from the group of coagulase-negative Staphylococci - CoNS (76.92%) in relation to the species Staphylococcus aureus (23.07%). According to the results from the susceptibility test antimicrobial, 87.5% of the samples identified as CoNS showed resistance to oxacilin, corroborating with previous studies that have estimated that the CoNS isolated in hospitals in Brazil, 70% to 90%, usually have shown resistance to oxacillin.17-19
During the last decades, the substantial increase in CoNS isolated in hospital settings, as well as their oxacillin resistance rates has increased significantly its clinical importance, becoming recognized as opportunistic agents often associated with nosocomial infections.17,19 As a result, it reinforces the importance of performing increasingly accurate cultures, especially as regards the antibiogram that will contribute to conduct towards the use of more rational way, in a more targeted therapy, particularly in hospital environment.
Since cases of sepsis are the most relevant and aggravating the clinical outcome of the patients was also evaluated in this study samples of blood cultures to check the connection of microorganisms present on nearby surfaces and its relation to the contamination of the patient. An 80% growth of Gram positive bacteria was observed in the analyzed blood cultures, with a prevalence of S. epidermidis (40%).
Similar data were observed in work carried out by Alves et al. (2012) involving 170 samples of blood cultures, which found 45.5% of S. epidermidis. In addition to this, there was a prevalence of 20% of S. haemolyticus, which also plays an important role in opportunistic infections. Infections caused by this species have been considered as a threat, since the mechanisms involved in biofilm formation between them, are not yet fully elucidated.15,17
The S. epidermidis and S. haemolyticus are the two species most frequently reported among the isolated CoNS in cases of nosocomial infections, according to several studies.18,20,21
Among the microorganisms identified as resistant to oxacillin, 12.5% of the species were similar in the bed surface samples and blood cultures from the same patient sample. The identification of microorganisms in hospital surfaces has been important in epidemiological investigations and suggest the environment as a possible source of transmission of nosocomial infections.15,17
One of the greatest ways to spread of hospital infections occur through cross-infection, which is caused by the transmission of microorganisms between patients or through the hands of professionals, caregivers and visitors, and health professionals the main contributors to this spread. The acquisition of microorganisms may also occur through direct contact with the patient material or contaminated environment.22,23 The low adherence of hygiene, by some health professionals, contributes to a significant increase of colonized patients, and consequently increasing the degree of environmental contamination. The aspects cleaning measures and disinfection of surfaces with handwashing contribute effectively as control measures in cases of cross-infections by minimizing the rise of environmental reservoirs, which may be considered as potential sources of infection to the patient.22
Because of the problem of global patient safety, the World Health Organization (WHO) established in 2004 the World Alliance for Patient Safety (World Alliance for Patient Safety) which seeks to define priority issues for research in the area of patient safety that are highly relevant.24 Among these, they highlight skills and abilities, often inadequate among health professionals and infections associated with health care.24,25
The similarity of microorganisms found between environmental samples and blood cultures in this study highlights the interference of the hospital in the transmission of pathogens and possible cross-infection. Resistant Gram positive bacteria identified reinforce the importance of emphasizing the general measures of environmental hygiene in relation to patient safety in health care. These include greater attention as handwashing, personal protective equipment for use, application of contact precautions, isolation area of establishment of patients with multidrug-resistant bacteria, as well as the strengthening of the institutional policy of rational use of antimicrobials.
REFERENCES
1 Cornejo-Juarez P, Vilar-Compte D, Pérez-Jiménez C, et al. The impact of hospital-acquired infections with multidrug-resistant bacteria in an oncology intensive care unit. Int J Infect Dis 2014; 31(2015): 31-34. http://dx.doi.org/10.1016/j.ijid.2014.12.022
2 Monteiro EL, Lacerda JT. Promoting the rational use of drugs: a proposal for an evaluation model of municipal management. Saúde Debate 2016; 111 (40): 101-116. http://dx.doi.org/10.1590/0103-1104201611108
3 Russotto V, Cortegiani A, Raineri SM, et al. Bacterial contamination of inanimate surfaces and equipment in the intensive care unit. J Intensive Care 2015; 3 (54): 1-8. http://www.dx.doi.org/10.1186/s40560-015-0120-5
4 Khan HA, Ahmad A, Mehboob R. Nosocomial infections and their control strategies. Asian Pac J Trop Biomed 2015; 5 (7): 509–514. http://dx.doi.org/10.1016/j.apjtb.2015.05.001
5 Levy CM. Manual de Microbiologia Clínica para o Controle de Infecção em Serviços de Saúde. ANVISA. 2004;381.
6 Previsdomini M, Gini M, Cerutti B, et al. Predictors of positive blood cultures in critically ill patients: a retrospective evaluation. Croat Med J 2012; 53 (1): 30-39. http://www.dx.doi.org/10.3325/cmj.2012.53.30
7 Malanovic N, Lohner K. Antimicrobial peptides targeting Gram-positive bacteria. Pharmaceuticals 2016; 9 (3): 59. doi: 10.3390/ph9030059
8 Becerra SC, Roy DC, Sanchez CJ, et al. An optimized staining technique for the detection of Gram positive and Gram negative bacteria within tissue. BMC Res Notes 2016; 9:216. 10.1186/s13104-016-1902-0
9 Ibrahim NK, Alwafi HA, Sangoof SO, et al. Cross-infection and infection control in dentistry: Knowledge, attitude and practice of patients attended dental clinics in King Abdulaziz University Hospital, Jeddah, Saudi Arabia. J Infect Public Health 2017; 10 (4): 438-445. http://dx.doi.org/10.1016/j.jiph.2016.06.002
10Dou JL, Jiang YW, Xie JQ, et al. New Is Old, and Old Is New: recent advances in antibiotic-aased, antibiotic-free and ethnomedical treatments against methicillin-resistant Staphylococcus aureus wound infections. Int J Mol Sci 2016; 17 (5): 617. doi: 10.3390/ijms17050617
11Ferreira IBP. Estudo dos fatores de virulência e resistência à oxacilina em Staphylococcus spp. isolados de aspirado traqueal de pacientes em ventilação mecânica internados em UTI Botucatu – São Paulo 2013 [monografia]. São Paulo: UEP; 2013.
12Maalej SM, Rhimi FM, Fines M, et al. Analysis of borderline oxacillin-resistant Staphylococcus aureus (BORSA) strains isolated in Tunisia. J Clin Microbiol 2012; 50 (10): 3345–3348. http://dx.doi.org/10.1128/JCM.01354-12
13Rocha IV, Ferraz PM, Farias TGS, et al. Resistance of bactéria isolated from equipment in an intensive care unit. Acta Paul Enferm 2015; 28 (5): 433-9. http://dx.doi.org/10.1590/1982-0194201500073
14Cordeiro ALAO, Oliveira MMC, Fernandes JD, et al. Equipment contamination in an intensive care unit. Acta Paul Enferm 2015; 28 (2): 160-5. http://dx.doi.org/10.1590/1982-0194201500027
15Otter JA, Yezli S, Salkeld JAG, et al. Evidence that contaminated surfaces contribute to the transmission of hospital pathogens and an overview of strategies to address contaminated surfaces in hospital settings. Am J Infect Control 2013; 41 (2013): 6-11. http://dx.doi.org/10.1016/j.ajic.2012.12.004
16Clinical Laboratory Standards Institute. Performance Standards for Antimicrobial Disk Susceptibility Tests; Approved Standard- Twenty-sixth edition. M100-S26. CLSI, 2016.
17Mohamad M, Deabate L, Belaieff W, et al. Prosthetic joint infections due to coagulase-negative Staphylococci. Int J Infect 2016; 3 (1): 1-8. http://dx.doi.org/10.17795/iji-32883
18Fowoyo PT, Ogunbanwo ST. Antimicrobial resistance in coagulase-negative Staphylococci from Nigerian traditional fermented foods. Ann Clin Microbiol Antimicrob 2017; 16 (4): 1-7. doi: 10.1186/s12941-017-0181-5
19Oliveira CF, Cavanagh JP, Fredheim EGA, et al. Coagulase-negative Staphylococci in Southern Brazil: looking toward its high diversity. Rev Soc Bras Med Trop 2016; 49 (3): 292-299. http://dx.doi.org/10.1590/0037-8682-0015-2016
20Pinheiro L, Brito CI, Oliveira A, et al. Staphylococcus epidermidis and Staphylococcus haemolyticus: molecular detection of cytotoxin and enterotoxin genes. Toxins 2015; 7 (9): 3688–3699. http://dx.doi.org/10.3390/toxins7093688
21Chessa D, Ganau G, Spiga L, et al. Staphylococcus aureus and Staphylococcus epidermidis virulence strains as causative agents of persistent infections in breast implants. PLoS ONE 2016; 11 (1): e0146668. https://doi.org/10.1371/journal.pone.0146668
22Sergent AP, Slekovec C, Pauchot J, et al. Bacterial contamination of the hospital environment during wound dressing change Bacterial contamination of the hospital environment during wound dressing change. Orthop Traumatol Surg Res 2012; 98 (2012): 441-445. http://dx.doi.org/10.1016/j.otsr.2012.02.005
23Messina G, Ceriale E, Lenzi D, et al. Environmental contaminants in hospital settings and progress in disinfecting techniques. Biomed Res Int 2013; 2013 (2013): 1-8. http://dx.doi.org/10.1155/2013/429780
24World Health Organization. (WHO). Patient safety–a global priority. Bull World Health Organ 2004; 82 (12): 891-970.
25Cimiotti JP, Aiken LH, Sloane DM, et al. Nurse staffing, burnout, and health care–associated infection. Am J Infect Control 2012; 40 (6): 486–490. http://dx.doi.org/10.1016/j.ajic.2012.02.029